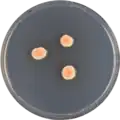

| Aspergillus deflectus | |
|---|---|
| Scientific classification | |
| Domain: | Eukaryota |
| Kingdom: | Fungi |
| Division: | Ascomycota |
| Class: | Eurotiomycetes |
| Order: | Eurotiales |
| Family: | Aspergillaceae |
| Genus: | Aspergillus |
| Species: | A. deflectus |
| Binomial name | |
| Aspergillus deflectus | |
| Type strain | |
| ATCC 16807, CBS 109.55, IMI 61448, NRRL 2206, QM 1904, UC4638, WB 2206[3] | |
Aspergillus deflectus is a species of fungus in the genus Aspergillus.[2][3] It produces a group of antimicrobial chemical compounds known as deflectins.[4] Aspergillus deflectus is in rare cases pathogenic.[5][6] It is from the Usti section.[7]
Growth and morphology
A. deflectus has been cultivated on both Czapek yeast extract agar (CYA) plates and Malt Extract Agar Oxoid (MEAOX) plates. The growth morphology of the colonies can be seen in the pictures below.
Aspergillus deflectus growing on CYA plate
Aspergillus deflectus growing on CYA plate Aspergillus deflectus growing on MEAOX plate
Aspergillus deflectus growing on MEAOX plate
References
- ↑ Fennell, D.I.; Raper, K.B. (1955). "New species and varieties of Aspergillus". Mycologia. 47: 68–89. doi:10.1080/00275514.1955.12024430.
- 1 2 "Aspergillus deflectus". www.mycobank.org.
- 1 2 "Aspergillus deflectus". www.uniprot.org.
- ↑ Bycroft, Barrie W. (1987). Dictionary of Antibiotics & Related Substances. CRC Press. ISBN 9780412254505.
- ↑ Powell, Natasha (2004). Botany. Lotus Press. ISBN 9788189093181.
- ↑ Safety, University of Minnesota, Department of Environmental Health &. "Aspergillus deflectus". www.dehs.umn.edu. Archived from the original on 2017-07-12. Retrieved 2017-12-09.
{{cite journal}}: CS1 maint: multiple names: authors list (link) - ↑ Samson, R.A.; Varga, J.; Meijer, M.; Frisvad, J.C. (2011). "New taxa in Aspergillus section Usti". Studies in Mycology. 69: 81–97. doi:10.3114/sim.2011.69.06. PMC 3161758. PMID 21892244.
Further reading
- Gupta, Vijai Kumar (2016). New and Future Developments in Microbial Biotechnology and Bioengineering: Aspergillus System Properties and Applications. Elsevier. ISBN 9780444635136.
- Rahman, Atta-ur- (2005). Studies in Natural Products Chemistry: Indices. Elsevier. ISBN 9780080481203.
- Jang, SS; Dorr, TE; Biberstein, EL; Wong, A (April 1986). "Aspergillus deflectus infection in four dogs". Journal of Medical and Veterinary Mycology. 24 (2): 95–104. doi:10.1080/02681218680000151. PMID 3723291.
This article is issued from Wikipedia. The text is licensed under Creative Commons - Attribution - Sharealike. Additional terms may apply for the media files.